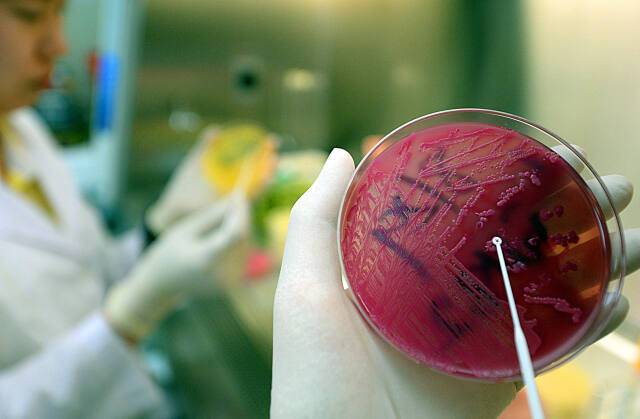
해당 기사와 직접적인 관련 없음. 경기일보DB

안성 중학생 40명 급식 먹고 식중독 증상
전체 맥락을 이해하기 위해서는 본문 보기를 권장합니다.
안성의 한 중학교에서 급식을 먹은 학생들이 집단 식중독 의심 증상을 보여 보건 당국이 역학조사에 나섰다.
23일 안성시보건소에 따르면 관내 A중학교에서 급식을 먹은 학생 등 40여명이 전날부터 설사와 복통 등 식중독 의심 증상을 보이고 있다는 신고가 들어와 현재 역학조사 중이다.
이 글자크기로 변경됩니다.
(예시) 가장 빠른 뉴스가 있고 다양한 정보, 쌍방향 소통이 숨쉬는 다음뉴스를 만나보세요. 다음뉴스는 국내외 주요이슈와 실시간 속보, 문화생활 및 다양한 분야의 뉴스를 입체적으로 전달하고 있습니다.
안성의 한 중학교에서 급식을 먹은 학생들이 집단 식중독 의심 증상을 보여 보건 당국이 역학조사에 나섰다.
23일 안성시보건소에 따르면 관내 A중학교에서 급식을 먹은 학생 등 40여명이 전날부터 설사와 복통 등 식중독 의심 증상을 보이고 있다는 신고가 들어와 현재 역학조사 중이다.
식중독 증상자 명단에는 교사 7명도 포함된 것으로 알려졌다.
지역 맘카페에는 같은 학교 학생 다수가 병원 응급실을 방문했다는 글이 올라오고 있다.
실제 A중학교 학생 수십명이 경기도의료원 안성병원과 평택 굿모닝병원 응급실을 방문해 치료를 받은 것으로 전해졌다.
보건 당국이 현장에 나가 조사한 결과 집중적으로 환자가 발생한 것은 전날 저녁이었으나, 이 학교에선 학생 3명이 전날 오전 10시 50분부터 메스꺼움 증상을 보여 보건실을 방문한 사실이 있는 것으로 나타났다.
보건 당국은 지난 19일부터 22일까지 해당 학교 급식의 보존식을 토대로 검사 중이다.
한편 A중학교는 이날 오전 단축 수업만 하고 학생들을 하교시켰다.
박석원 기자 swp1112@kyeonggi.com
Copyright © 경기일보. 무단전재 및 재배포 금지.
- “근로자 1만 4천명 몰리는데”…용인 반도체 현장 ‘치안 비상’
- 배우 조보아, 결혼 1년여 만에 득남…“산모·아이 모두 건강”
- 청라하늘대교 개통 한 달…영종대교 ‘22% 급감’, 인천대교 ‘소폭 상승’ [집중취재]
- “아들 데려가던 아버지, 그만”...음주운전으로 가장 숨지게 한 50대 ‘실형’
- [단독] 인천 강화서 전기차 화재...택시기사 사망
- 국민의힘 원외 71명 “장동혁 정당성 흔들기 중단하라”
- “마을 안으로, 시민 속으로”…강화군, 인구증가 대응 위해 인천시와 통합회의
- 태진아, 전한길 콘서트 출연설에 “사실무근” 법적 대응 예고
- “당대표 흔들기 멈춰라”...박종진·김기흥 등 인천 위원장 5인, 장동혁 사퇴 요구에 ‘맞불’
- ‘금값 된 GPU만’...평택 컴퓨터 부품점서 1천600만원 피해